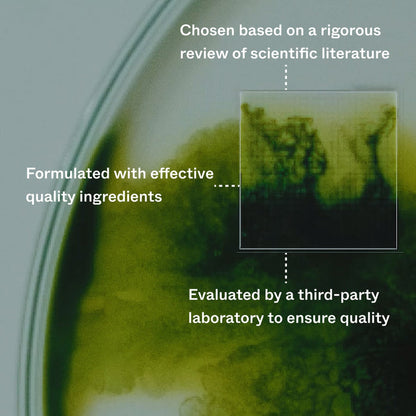
Seurico™ Follicle Boost Activation Serum

Results demonstrated after 150 days
We have developed and trademarked the Seurico™ Follicle Boost formula, which has been clinically tested in a proprietary third-party study. Our Follicle Boost Activation Serum demonstrated the following results:
97% experience less hair loss
93% had a clinically tested reduction in hair loss
73% had a clinically tested increase in hair density

Real people, real results
We are committed to using effective active ingredients to create products that help users achieve their hair goals. Recently, a survey of 440 of our customers provided us with valuable insights into their experiences and preferences:
85% of users prefer Seurico over all other solutions they have tried
74% of users prefer Seurico over conventional drug-based products
92% of users prefer Seurico over only using caffeine infused shampoos
Effective active ingredients
Formulated with effective quality ingredients. Every active ingredient has been chosen based on a rigorous review of scientific literature and are all evaluated by a third-party laboratory to ensure quality. All ingredients are 100% vegan. The formula is inspired by nature, with many of the active ingredients being either naturally-derived or produced to mimic the exact same molecular structure.

Capilia Longa
An effective natural compound that demonstrated up to 89% reduction in hair loss and up to 52% improvement in hair density in individual studies.
Derived from the plant Curcuma Longa, Capilia Longa offers several benefits for the hair. Rich in plant growth factors, it can help to reactivate growth in dormant hair follicles while providing nourishment for optimal growth.
BENEFITS
- Can measurably reduce hair loss
- May visibly increase hair density after 150 days
- Helps keep hair strong by extending the life of hair fibers

Niacinamide
Niacinamide can contribute to stronger hair by stimulating keratin production, the key protein making up about 90% of the hair shaft.
In addition to its keratin-boosting potential, niacinamide can improve blood flow and protect hair follicles from damage caused by oxidative stress.
BENEFITS
- Can strengthen hair by stimulating keratin production
- Helps protect from oxidative stress
- Helps reduce hair loss by improving blood flow

Vanillyl Butyl Ether
A mild warming agent that can create a warm, tingling sensation on the scalp. This can improve blood flow – and so nutrient and oxygen delivery – to the scalp.
To be able to grow hair, follicles need oxygen and nutrients. Vanillyl Butyl Ether can help improve the delivery of these essentials to the follicle by increasing blood flow.
BENEFITS
- Helps to improve blood flow to the scalp
- Contributes to increased oxygen & nutrient delivery
- Encourages hair growth
Hair loss can be reduced
As long as there are active hair follicles, there is a chance for growth. But how to know if they’re active? In most early-stage hair loss cases, the follicles are still capable of growing hair. They just need some help.

WHAT'S THE CAUSE OF HAIR LOSS?
Hair loss can be triggered by many factors: genetics,hormones, medication, illness, or lifestyle. But often, these allaffect one crucial thing:
The hair's growth cycle.
Ideally, around 90% of your hairs are actively growing at anyone time (growth phase). The remaining 10% are in theirresting & shedding phase.
Hair loss happens when these numbers shift toward theshedding phase.

THE SOLUTION
To stop shedding and grow hair, two things need to happen:
1. An increase in the number of hairs in the growth phase.
2.A decrease in the number of hairs in the shedding phase.
While you may not have control over factors like your genetics,research shows that it is possible to rebalance the hair growthcycle.
And often, it can be done by giving nature a helping hand,without medication.

CLINICALLY TESTED HAIR GROWTH,WITHOUT DRUGS
In our clinical trial, 30 men and women with variousbackgrounds used the Follicle Boost Activation Serum daily for150 days. Testing found that the serum can help increase thegrowth phase and decrease the shedding phase.
How did this translate into real-life results?
93% were satisfied with the results
93% had measurably less hair loss
73% had a clinically tested increase in hair density
Got questions? We've got answers.
When will the results begin to show?
When will the results begin to show?
A clinical efficacy testing of our Follicle Boost Formula found that for many participants reduced hair loss could bemeasured after 45 days of use. However, it usually takes 150 days to see significant effects of the Follicle Boost.
Is it normal to feel a 'warm' sensation when applying the Follicle Boost Activation Serum?
Is it normal to feel a 'warm' sensation when applying the Follicle Boost Activation Serum?
A 'tingling’ or "burning’ sensation is typically felt upon application of the Follicle Boost Activation Serum, which isconsidered a normal reaction when using the serum. The sensation is attributed to the heating agent HotFluxe, orvanillyl butyl ether, which helps to rejuvenate hair growth.
The intensity varies depending on the individual, ranging from minimal notability to irritability. Most cases aremild, but in rare instances, redness and tenderness may occur. lf experiencing any additional side effects,discontinue use and consult a medical professional. Please report any additional side effects to customer care.
Is the Follicle Boost Formula dermatologically tested?
Is the Follicle Boost Formula dermatologically tested?
Yes, patch tests were performed under dermatological control on a group of 25 volunteers with normal skin. in thetested group of volunteers there were no irritations or allergic reactions.
Are the products allergen-free?
Are the products allergen-free?
Although all our products are dermatologically tested, they are not allergen-free. Vanilyl butyl ether andeucalvptus ol wimonene have sensitising properties, meaning thev can evoke allergies for certain individuals, it ishighly encouraged to check all ingredients before starting to ensure you do not suffer from any allergies of theisted ingredients.
If unsure, perform a patch test before application. To perform a patch test simply apply a small amount of theproduct onto a clean area of skin on the upper forearm, following 24 hours rinse the area. lf any redness, itching,blistering or irritation is observed at any time throughout the test, do not use the product.
Why is there alcohol in the Follicle Boost Serum?
Why is there alcohol in the Follicle Boost Serum?
The alcohol in the Follicle Boost formulation is essential to enable the effect of active ingredients. The alcohol serves
as an agent to optimise the scalp environment.
Where can l find the results of the clinical study?
Where can l find the results of the clinical study?
You can read more about the results and methodology of the clinical testing of the Follicle Boost Formula here

Results Visible in 150 Days
Step 1: Document your journey
Take a photo of the treated area each month, starting pre-treatment. You might be surprised at how much progress you'vemade!
Step 2: Use the Activation Serum daily
Make sure to apply Activation Serum every day, even if you skipthe shampoo and conditioner.
Step 3: Stick to it for 150 days
Use at least five bottles of Activation Serum over a 150-day period.This is the period in which our clinical test showed noticeableresults for 97% of participants.